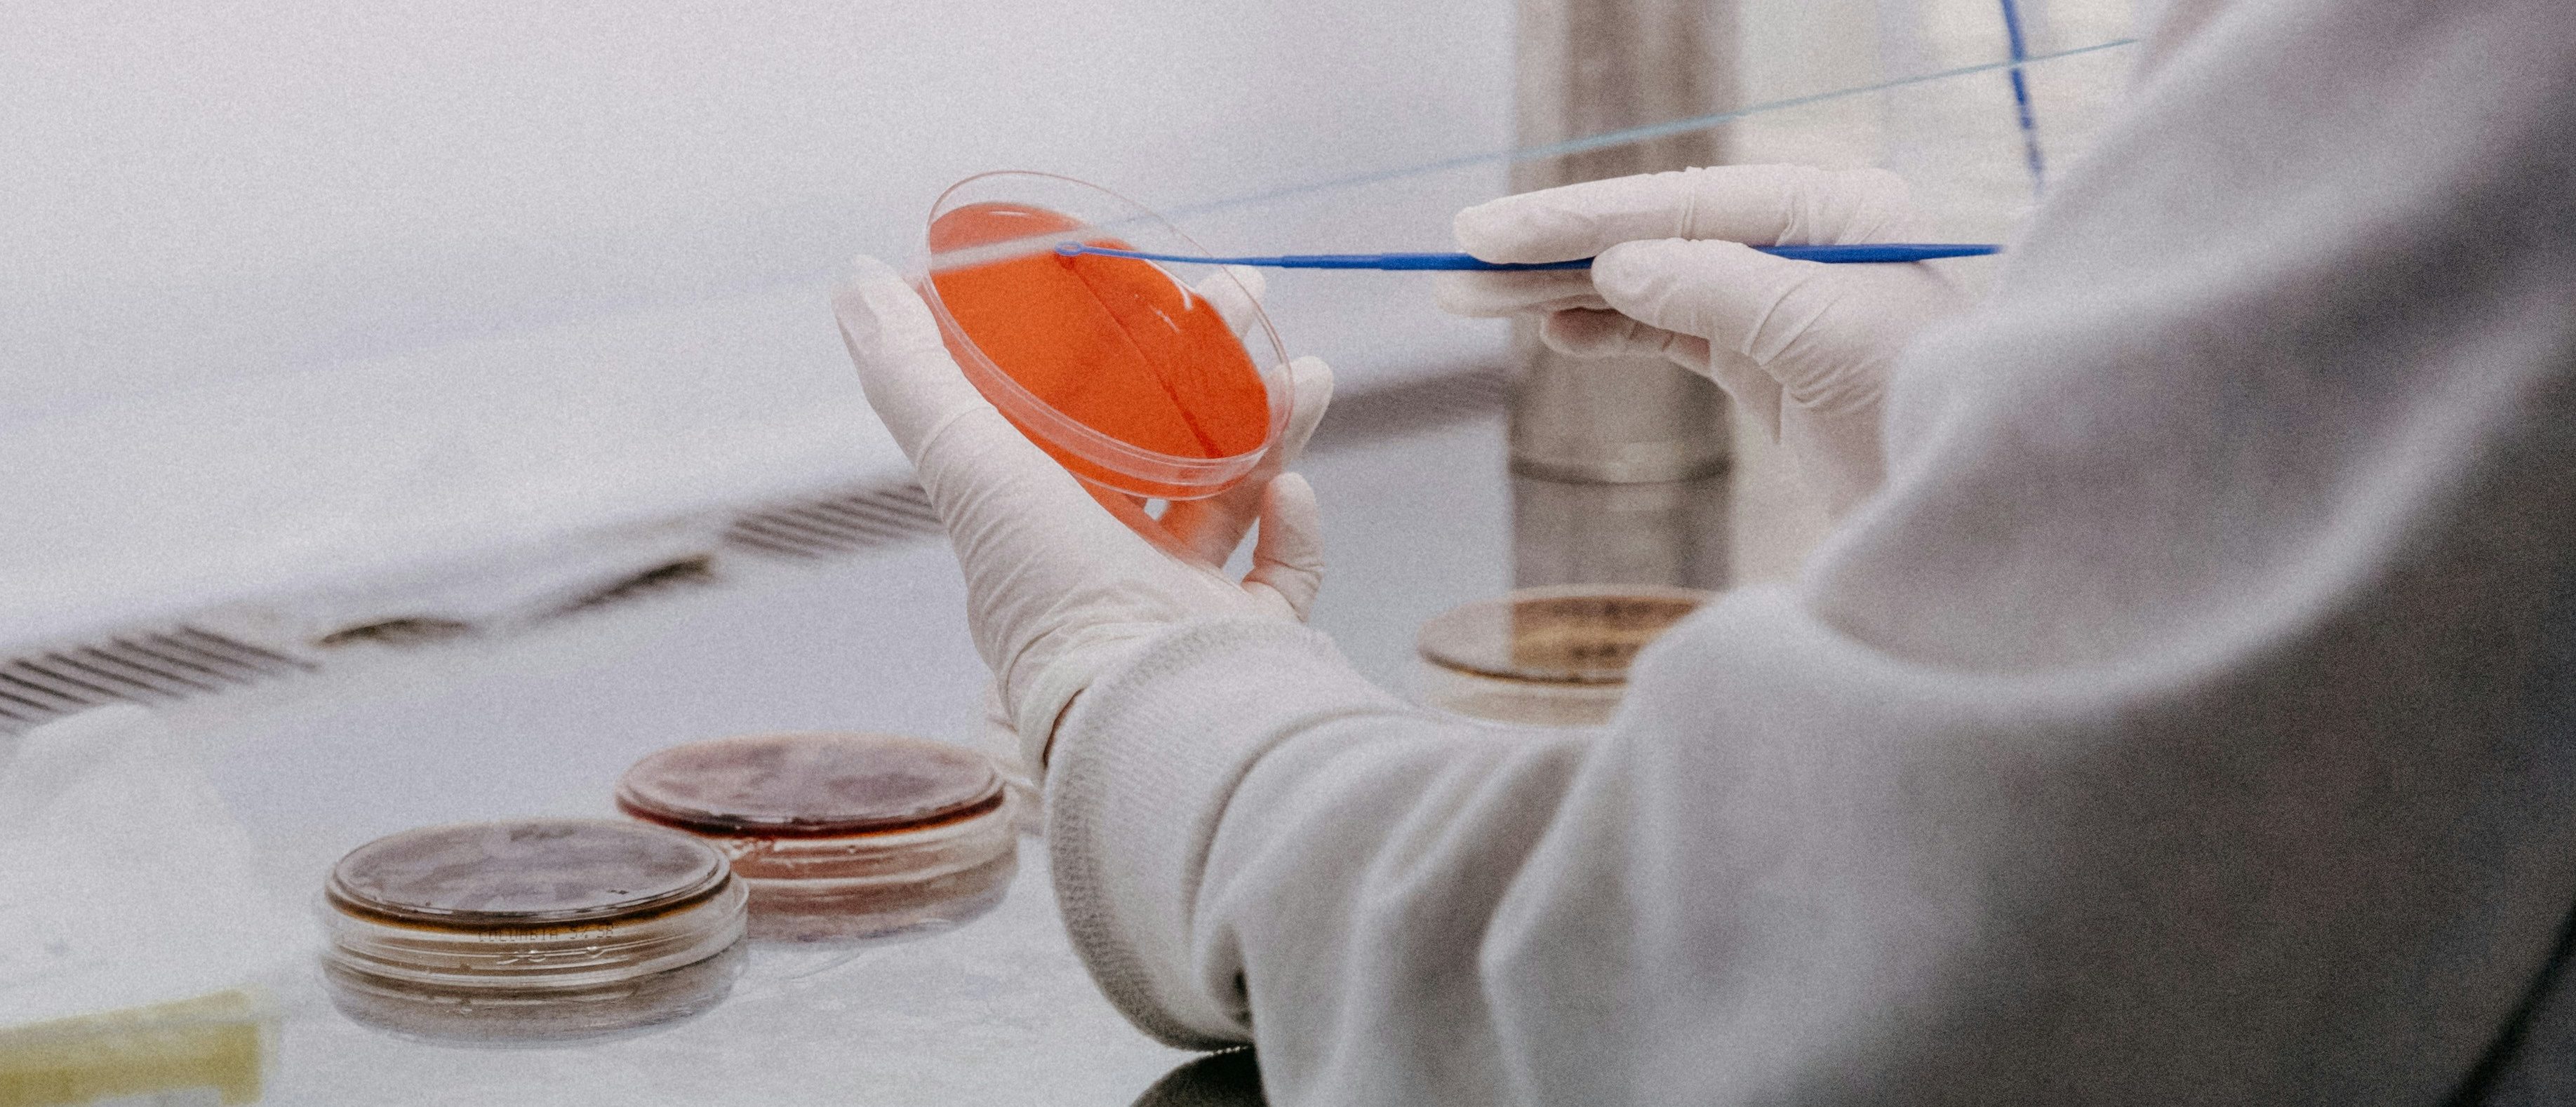

Healthcare
‘It’s A Good Start’: Trump’s NIH Takes Step To Hold Risky Research Labs Accountable
Trnava University/Unsplash
The U.S. lacks a formal warning system to alert the public about lab leaks, but under new guidance implemented Sunday, the Trump administration will now require labs to publicly post details about genetic engineering research and accidental infections.
Hundreds of Institutional Biosafety Committees (IBCs) serve as the local overseers of potential biohazards. IBCs at research universities, federal labs, biotechnology companies and hospitals review risky experiments and discuss gain-of-function research that makes viruses more deadly or transmissible in the lab. IBCs also review lab accidents and potential exposures to infectious agents like viruses.
Now, new National Institutes of Health (NIH) rules now require IBCs to publish all of their future meeting minutes immediately following approval by the research intuition.
In principle, the NIH requires the reporting of major lab leaks. In practice, IBCs operated without much transparency or accountability from government funders, biosafety advocates say.
Despite their centrality to policing risky research, the NIH previously did not require intuitions to provide their IBC meeting minutes directly to the agency. IBCs were only required to provide minutes if members of the public requested them.
Maintaining an up-to-date window into high-risk research and biosafety breaches would have required an individual compiling IBC records by request across hundreds of intuitions every few months, while some institutions stonewall advocates and journalists, according to reports in USA Today and Undark.
Complaint against @USC filed with NIH. The University of Southern California plans massive and very dangerous aerosol experiments with #H5N1 and other RG3 and RG4 disease agents, and it is not responding to requests for its biosafety committee minutes. @HHSGov pic.twitter.com/NOnewcZK42
— Edward Hammond (@pricklyresearch) February 23, 2025
While not a formal lab accident database, publicly-available records of the meetings of IBCs around the country could provide new insight into potential lab-made biohazards and near-misses. A March 28, 2025, guide notice first spelled out the new rules.
The NIH in recent days also posted the makeup and contact information for hundreds of IBCs. As recently as May 27, the NIH maintained a list of institutions with IBCs without any information on the individuals on the committees or how the public could reach them.
Information about dangerous lab accidents should never be exempt from FOIA, but we can do even better.
The US should lead the way in transparency with public databases of all lab acquired infections, all lab incidents involving potential pandemic pathogens, and all IBC records. https://t.co/XDpYQQHOet
— Tyler Stepke (@TylerAStepke) December 18, 2024
Public access to information about the nation’s portfolio of high-risk research is a positive step forward, but more action is required to stamp out unacceptably risky research that should not be conducted at all, some experts say.
“It’s a good start, but the NIH has much more work to do to improve biosafety and biosecurity beyond simply listing IBC rosters and minutes,” said Laura Kahn, a pandemic expert and author of the book “One Health and the Politics of COVID-19,” in an email to the Daily Caller News Foundation. “They have to incorporate bioethics, and that will require developing the policies and procedures to evaluate biomedical research proposals to weed out dangerous work in which the risks outweigh the benefits.”
A May 5 executive order initiated an interagency process to hammer out new guidance that NIH Director Jay Bhattacharya has said will result in a ban on dangerous gain-of-function research.
Jay Bhattacharya on Gain-of-Function Research
“This is a foolhardy way to pretend to yourself that we’ve protected ourselves against a pandemic when we haven’t … And I think it’s very likely that the COVID pandemic was the result of this kind of research.” pic.twitter.com/ddJSCFHrvq
— Chief Nerd (@TheChiefNerd) May 30, 2025
“What we want is to make sure researchers understand that they should not be doing research that has the chance of causing a pandemic,” Bhattacharya said in an interview with the Hoover Intuition on May 28. “Are you doing an experiment, where even if you think you have a benign virus, a bat virus from the middle of nowhere that doesn’t seem to infect humans, are you doing experiments that augment them that might infect humans and cause a pandemic? Then you shouldn’t be doing that.”
“Universities, NGOs, should understand that if they allow that kind of work to go and they don’t have that as part of the regulatory process … if they sort of surreptitiously do it and it’s only discovered ex-post, they’re going to face essentially existential threats,” he said. “It’s so dangerous, it’s like allowing everyone in the United States to have their own nuclear reactor.”
NIH didn’t immediately respond to a request for comment.
All content created by the Daily Caller News Foundation, an independent and nonpartisan newswire service, is available without charge to any legitimate news publisher that can provide a large audience. All republished articles must include our logo, our reporter’s byline and their DCNF affiliation. For any questions about our guidelines or partnering with us, please contact [email protected].

